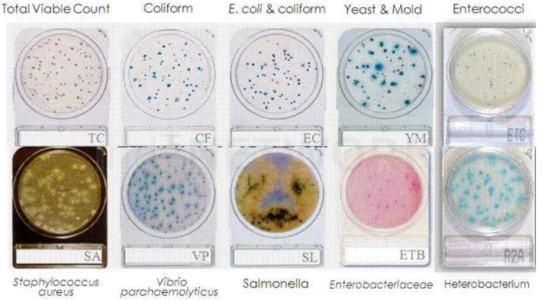
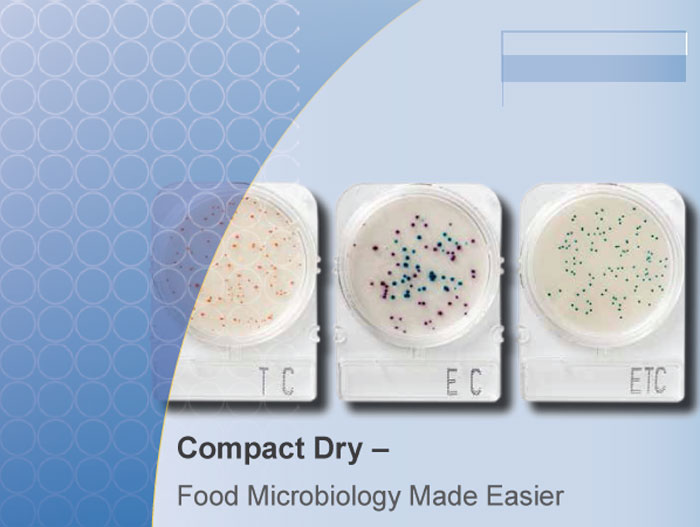
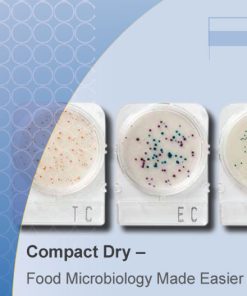

Compact Dry – Đĩa môi trường đông khô đổ sẵn của Nissui dựa trên cơ chế phát hiện vi sinh vật, dựa trên phản ứng của các enzyme do vi sinh vật sinh ra trong quá trình nuôi cấy với các cơ chất chuyên biệt sinh ra các khuẩn lạc với các màu sắc đặc trưng.
Hãng: Nissui
Xuất xứ: Nhật Bản
Đặc điểm
Sẵn sàng để sử dụng
– Không cần khử trùng
– Tiết kiệm thời gian, nước và năng lượng
– Tránh được hàng loạt các ô nhiễm.
Tiện lợi
– Quy trình công việc hợp lý hơn
– Nhiệt độ ủ đồng đều 35 độ C cho hầu hết các thông số ngoại trừ nấm men và nấm mốc (25 độ C) và Salmonella 41 độ C)
– Kiểm tra vi sinh vật trong 3 bước dễ dàng: cấy, ủ và giải thích kết quả.
Mẫu tự khuếch tán
– Mẫu tự động khuếch tán đúng 10 giây sau khi nhỏ mẫu.
– Loại bỏ việc sử dụng các phụ kiện hay vật tư tiêu hao khác như dụng cụ dùng để trang mẫu.
– Không có thời gian gelling, một phương tiện truyền vào miếng vải dễ dàng hóa rắn khi nhỏ mẫu vào.
– Không cần nhấn, trải và nghiêng đĩa.
Cho kết quả nhanh và chính xác
– Kết quả nhanh nhất là 24 đến 48 giờ đối với hầu hết các chỉ tiêu.
– Không cần thêm đĩa xác nhận và thủ tục
– Độ tương phản màu sắc khác biệt để nhận dạng khuẩn tốt hơn
– Phân biệt dễ dàng hơn giữa nấm men và nấm mốc do không gian cho phép tăng trưởng 3D.
– Dễ dàng chọn các không gian bị cô lập để phân tích thêm.
Thiết kế sáng tạo
– Đĩa nhỏ gọn với nắp đậy, nắp rất chắc chắn để tránh nhiễm bẩn và tràn vào đĩa.
– Với vùng ghi không dễ bị xóa do kết cấu của nhựa mờ.
– Được thiết kế với tay cầm gọn nhỏ và không gian thoáng khí để phân phối oxy đều
– Đĩa có khả năng xếp chồng không giới hạn tùy theo công suất của tủ ủ mà không ảnh hưởng đến sự phát triển của vi sinh vật.
Bao bì bắt mắt
– Ổn định ở nhiệt độ phòng trong vòng 18 đến 36 tháng
– Các đĩa được nhóm để nhóm một loại mẫu với nhiều độ pha loãng
– Các đĩa cũng có thể được phá vỡ chỉ để sử dụng một lần
– Đóng gói 4 đĩa trong 1 gói để tránh ảnh hưởng của thời hạn sử dụng thứ cấp (30 ngày) khi mở giấy bạc.
– Đĩa được công nhận theo tiêu chuẩn quốc tế: AOAC International, European Microval, NordVal và HPFB Health Canada.
Nhiều chỉ tiêu và ứng dụng cho hầu hết các lĩnh vực
– Hiện tại, sản phẩm đĩa Compact Dry có tất cả 12 chỉ tiêu
– Compact Dry được ứng dụng rộng rãi hầu hết cho tất cả các lĩnh vực: chế biến bánh kẹo, nước giải khát, chế biến sữa, chế biến thịt, chế biến snacks, chế biến rau quả, chế biến thủy hải sản, sản xuất đường, thức ăn chăn nuôi, dược phẩm, mỹ phẩm, sản xuất nước uống.

Đánh giá
Chưa có đánh giá nào.